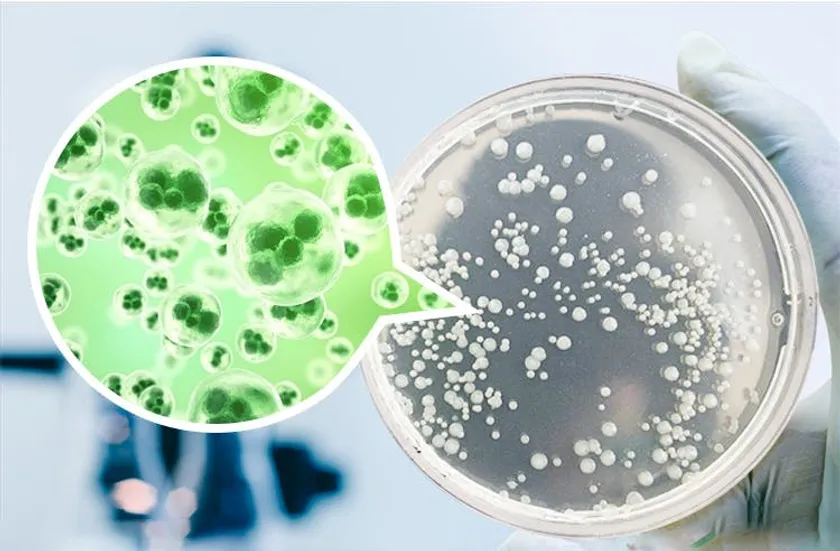

歯ブラシを清潔にする「RB1」歯磨き粉ディスペンサー付き 歯ブラシホルダープロジェクト始動
LIFE Trading(代表:八波 貴之)は、皆様に清潔な歯ブラシを使っていただくことを目的に2021年3月13日「CAMPFIRE」のクラウドファンディングを開始しました。
URL: https://camp-fire.jp/projects/view/394961

タイトル
【プロジェクト開始の背景】
必ず毎日使用する歯ブラシ、お手入れは正しくできていますか?“正しいお手入れ”ができていない歯ブラシは、一晩で約18,000個の菌が繁殖すると言われています。

一晩で約18,000個の菌が繁殖
菌が繁殖した歯ブラシを使用しての歯磨きは、まったくの逆効果。虫歯や口臭など、さまざまなお口トラブルの原因となってしまいます。
今回のプロジェクトは、そんな見えない部分まで解決する優れモノの商品プロジェクトが始動いたしました。
【商品の特長】
(1) 99%のUV-C除菌!
「RB1」は、病院などでも数多く応用されている紫外線除菌を採用。中でも強い除菌効果を持つUV-C(波長200~275nm)で、除菌率は99%を実現!さらに、ブルーライトの光触媒で除菌をサポート。UV-C紫外線を浴びることで、除菌を促進してくれる働きを持ちます。

ブルーライトの光触媒で除菌をサポート
歯磨きが終わったら歯ブラシを収納してOK。電源ボタンを押し離れて放置。
除菌が完了。それだけでありません。歯ブラシは除菌後も細菌は増えます。
だから、6時間ごとに自動で除菌開始!いつでも清潔な歯ブラシを使えます!
終了したい場合は電源ボタンを再度押して終了です!
※除菌中のライトは直視しないでください。
24時間放置した様子
▲これは歯磨き後の歯ブラシを水洗いして、24時間放置した様子。菌が繁殖しているのがよく分かります…。
(2) 歯磨き粉ディスペンサー搭載。

説明書
歯磨き粉ディスペンサー付きなので、適量の歯磨き粉を出すことができます!
さらに、取り外して洗浄可能なのでいつでも衛生的に使用可能です!
(3) どこにでも設置できる接着シールタイプ

ホワイト

ブラック
●RB1で洗面所の快適生活を。
RB1はごちゃごちゃしがちの洗面所周りをすっきりさせるのにも最適です。
是非RB1のある暮らしをお試しください!
【リターンについて】
超超早割:「RB1」1個セット(税・送料込)
10名様限定価格!
<一般販売予定価格の12,800円から40%オフ>
超早割:「RB1」1個セット(税・送料込)
15名様限定価格!
<一般販売予定価格の12,800円から30%オフ>
早割:「RB1」1個セット(税・送料込)
<一般販売予定価格の12,800円から25%オフ>
【プロジェクト概要】
プロジェクト名: 歯ブラシを清潔にする
「RB1」歯磨き粉ディスペンサー付き歯ブラシホルダー
期間 : 2021年3月13日~2021年4月26日
URL : https://camp-fire.jp/projects/view/394961
【会社概要】
屋号 : LIFE Trading
代表者 : 八波 貴之
事業内容 : 貿易

















